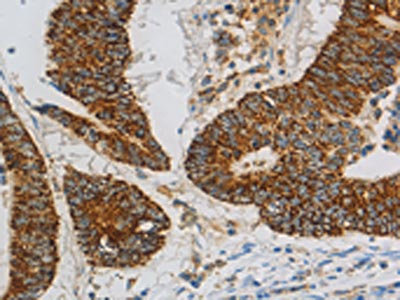

CCNF Antibody
-
中文名稱:CCNF兔多克隆抗體
-
貨號(hào):CSB-PA698741
-
規(guī)格:¥1100
-
圖片:
-
其他:
產(chǎn)品詳情
-
Uniprot No.:
-
基因名:CCNF
-
別名:Ccnf antibody; CCNF_HUMAN antibody; Cyclin-F antibody; F box only protein 1 antibody; F-box only protein 1 antibody; FBX1 antibody; FBXO1 antibody; G2 mitotic specific cyclin F antibody; G2/mitotic specific cyclin F antibody
-
宿主:Rabbit
-
反應(yīng)種屬:Human
-
免疫原:Fusion protein of Human CCNF
-
免疫原種屬:Homo sapiens (Human)
-
標(biāo)記方式:Non-conjugated
-
抗體亞型:IgG
-
純化方式:Antigen affinity purification
-
濃度:It differs from different batches. Please contact us to confirm it.
-
保存緩沖液:-20°C, pH7.4 PBS, 0.05% NaN3, 40% Glycerol
-
產(chǎn)品提供形式:Liquid
-
應(yīng)用范圍:ELISA,IHC
-
推薦稀釋比:
Application Recommended Dilution ELISA 1:2000-1:5000 IHC 1:25-1:100 -
Protocols:
-
儲(chǔ)存條件:Upon receipt, store at -20°C or -80°C. Avoid repeated freeze.
-
貨期:Basically, we can dispatch the products out in 1-3 working days after receiving your orders. Delivery time maybe differs from different purchasing way or location, please kindly consult your local distributors for specific delivery time.
-
用途:For Research Use Only. Not for use in diagnostic or therapeutic procedures.
相關(guān)產(chǎn)品
靶點(diǎn)詳情
-
功能:Substrate recognition component of a SCF (SKP1-CUL1-F-box protein) E3 ubiquitin-protein ligase complex which mediates the ubiquitination and subsequent proteasomal degradation of target proteins. The SCF(CCNF) E3 ubiquitin-protein ligase complex is an integral component of the ubiquitin proteasome system (UPS) and links proteasome degradation to the cell cycle. Mediates the substrate recognition and the proteasomal degradation of various target proteins involved in the regulation of cell cycle progression and in the maintenance of genome stability. Mediates the ubiquitination and proteasomal degradation of CP110 during G2 phase, thereby acting as an inhibitor of centrosome reduplication. In G2, mediates the ubiquitination and subsequent degradation of ribonucleotide reductase RRM2, thereby maintaining a balanced pool of dNTPs and genome integrity. In G2, mediates the ubiquitination and proteasomal degradation of CDC6, thereby suppressing DNA re-replication and preventing genome instability. Involved in the ubiquitination and degradation of the substrate adapter CDH1 of the anaphase-promoting complex (APC/C), thereby acting as an antagonist of APC/C in regulating G1 progression and S phase entry. May play a role in the G2 cell cycle checkpoint control after DNA damage, possibly by promoting the ubiquitination of MYBL2/BMYB.
-
基因功能參考文獻(xiàn):
- A single missense mutation in cyclin F causes hyper-ubiquitylation of proteins that can indirectly impair the autophagy degradation pathway, which is implicated in amyotrophic lateral sclerosis pathogenesis. PMID: 28852778
- Cyclin F and ribonucleotide reductase family member 2 (RRM2) compose a functional axis responsible for nucleotide metabolism. Impairment in this pathway may contribute to increased DNA damage repair and drug resistance. Additionally, we analyzed the expression of RRM2 mRNA and discovered that high expression of RRM2 is associated with worse overall survival. PMID: 29767233
- Mutational spectrum of CCNF emphasizes the pathogenic role of CCNF mutations in ALS. PMID: 29102476
- Our result indicates that the mutation of CCNF is rare in patients with amyotrophic lateral sclerosis and frontotemporal dementia from Mainland China PMID: 28281833
- These data indicate that the coordinated, temporal ordering of cyclin F and Cdh1 degradation, organized in a double-negative feedback loop, represents a fundamental aspect of cell-cycle control PMID: 27653696
- Authors demonstrated a significant correlation between the severity of the CCNF-induced axonopathy and a reduced motor response to a light stimulus (photomotor response). PMID: 28444311
- Cyclin F-mediated degradation of SLBP limits H2A.X accumulation and apoptosis upon genotoxic stress in G2 cell cycle checkpoint. PMID: 27773672
- cyclin F is a novel F-box protein that functions as an intrinsic cellular regulator of HIV-1 Vif and has a negative regulatory effect on the maintenance of viral infectivity by restoring APOBEC3G expression PMID: 28184007
- The SCYL1- BP1 affects the cell cycle through increasing steady state levels of Cyclin F and RRM2 proteins, thus constituting a dual regulatory circuit. PMID: 25980818
- Data indicate that a missense mutation in cyclin F (CCNF) in a large Amyotrophic lateral sclerosis (ALS) and frontotemporal dementia (FTD) family. PMID: 27080313
- CDC6 and Cyclin F interact through defined sequence motifs that promote CDC6 ubiquitylation and degradation. PMID: 26818844
- Cyclin F suppresses B-Myb activity to promote cell cycle checkpoint control. PMID: 25557911
- Cyclin F controls genome stability through ubiquitin-mediated proteolysis. (Review) PMID: 23182110
- After DNA damage, cyclin F is downregulated in an ATR-dependent manner to allow accumulation of RRM2. Defective elimination of cyclin F delays DNA repair and sensitizes cells to DNA damage, a phenotype that is reverted by expressing a nondegradable RRM2 mutant. PMID: 22632967
- SCF(Cyclin F)-mediated degradation of CP110 is required for the fidelity of mitosis and genome integrity PMID: 20596027
- degradation during G2-M by mechanisms fundamentally different from other cyclins PMID: 12122006
顯示更多
收起更多
-
亞細(xì)胞定位:Nucleus. Cytoplasm, perinuclear region. Cytoplasm, cytoskeleton, microtubule organizing center, centrosome, centriole.
-
蛋白家族:Cyclin family, Cyclin AB subfamily
-
組織特異性:Widely expressed, with expression detected in the heart, brain, placenta, lung, liver, skeletal muscle, kidney and pancreas.
-
數(shù)據(jù)庫鏈接:
Most popular with customers
-
YWHAB Recombinant Monoclonal Antibody
Applications: ELISA, WB, IHC, IF, FC
Species Reactivity: Human, Mouse, Rat
-
Phospho-YAP1 (S127) Recombinant Monoclonal Antibody
Applications: ELISA, WB, IHC
Species Reactivity: Human
-
-
-
-
-
-